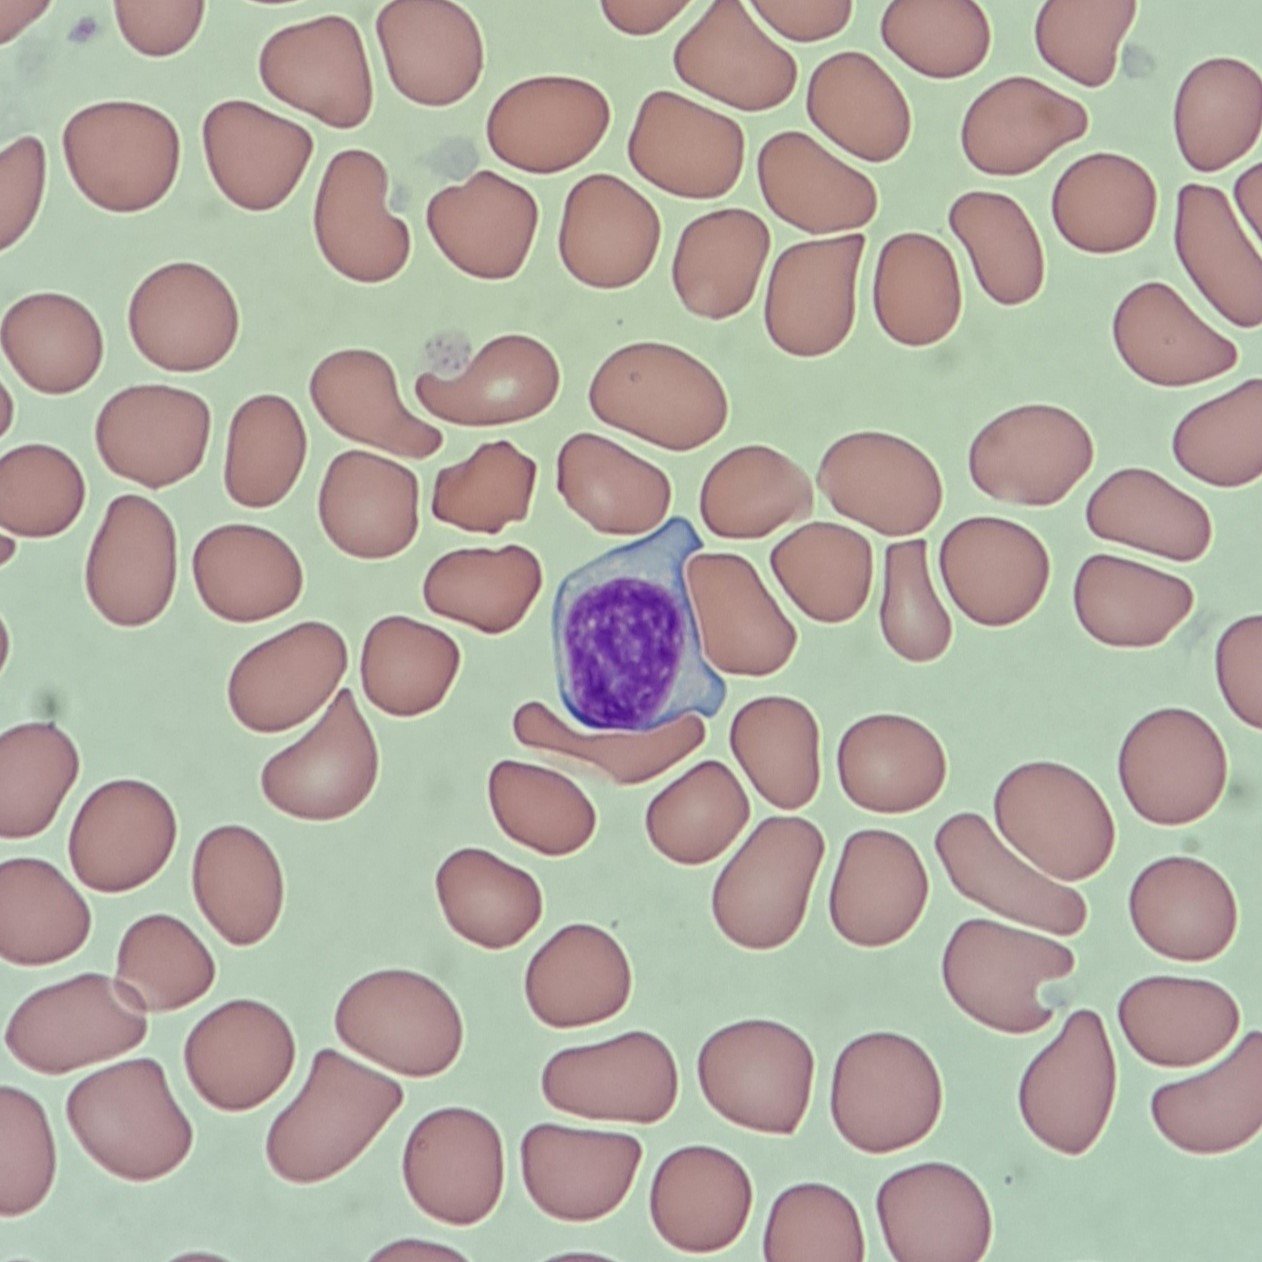
Activated Lymphocyte, White Blood Cell

Cell Comparison
Nucleus
- Nucleoli Present
- Fine Chromatin
- No Nucleoli
- Loose Chromatin
Cytoplasm
- (Usually) Scant Cytoplasm
- Basophilic Cytoplasm
- Abundant Cytoplasm
- Translucent-looking Cytoplasm with Basophilic Peripheral
More Cell Comparison
Blast Cells



Activated Lymphs



Patient Picture
The most important tool when deciding cell type is patient picture. What makes more sense for the patient? If they have an increased lymphocyte count due to a viral infection, it would make sense to see some activated lymphs. Blasts however, are not typically seen in response to infection and usually indicate a myeloproliferative or myelodysplastic disorder. Blasts may be accompanied by drastically increased white count or other immature white blood cells. If a suspected blast is seen, it is a good idea to compare it to the other cells in the smear to confirm.